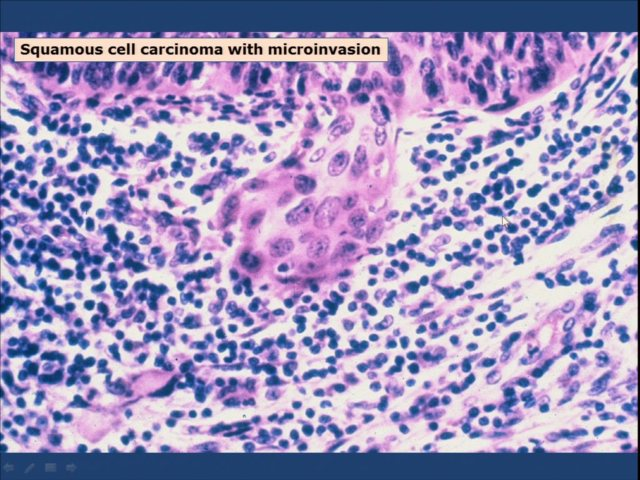
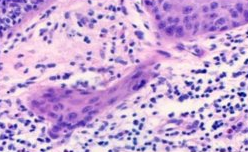

1
Q

A

2
Q

A

3
Q

A
ASC-US
4
Q

A
5
Q

A

6
Q

A

7
Q

A
Cervical cancer
8
Q

A

9
Q

A

10
Q

A

11
Q

A

12
Q

A

13
Q

A

14
Q

A

15
Q

A

16
Q

A

17
Q

A

18
Q

A
HSIL / CIN3
19
Q

A

20
Q

A
LSIL / CIN1
21
Q
A
Microinvasion
22
Q
Normal or abnormal?

A
Normal
23
Q

A

24
Q

A

25


26

Transformation zone
27


28


29


30


31
What strains of HPV does the 2006 vaccine protect against?
6, 11, 16, 18
32
What are the functions of the E6 viral protein?
- interrupt cell death pathways by binding p53
- induce centrosome duplication, genomic instability
- upregulate telomerase
33
What are the functions of the E7 viral protein?
- disrupt cell cycle by RB binding with upregulation of cyclin E and p16INK4
- induce centrosome duplication, genomic instability
34
What does CIN stand for?
Cervical interepithelial neoplasm


